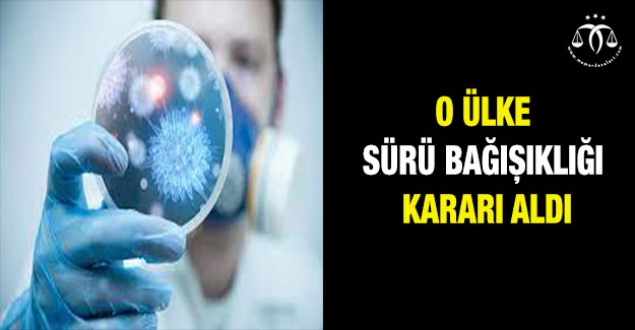

|
Tweet |
Son aylarda koronavirüs aşısı tartışmalarının odağına oturan AstraZeneca'dan art arda flaş haberler gelmeye devam ediyor. Avrupa İlaç Ajansı (EMA) yan etki konusunda yeni kararını açıklarken aşının kendi ülkesi İngiltere de kritik bir adım attı. Ülkede 30 yaş altı kişiler bundan böyle AstraZeneca aşısı yaptıramayacak.
Sağlık Bakanı Matt Hancock konuyla ilgili yeni bir açıklama yaparak 18-29 yaş aralığındaki kişilere Pfizer ya da Moderna aşılarından biri kendi seçimlerine göre yapılacak derken 'aşılardan elimizde çokça var, endişeye mahal yok.' ifadesini kullandı.
NÜFUSUN YÜZDE 73,4'ÜNE ULAŞILDI
Öte yandan aşı krizini çözmeye çalışan ülkeden dünyayı heyecanlandıran bir açıklama daha geldi. College London Üniversitesi'nin (UCL) oluşturduğu modellemeye göre İngiltere önümüzdeki pazartesi günü yani 12 Nisan'dan itibaren sürü bağışıklığına girecek. Üniversitenin modellemesi Kovid-19'a karşı bağışıklık kazanan nüfusun %73.4'e ulaşması sayesinde oluşturuldu.
UCL tarafından yayınlanan araştırmada, koronavirüse karşı aşı yoluyla veya önceden geçirdiği enfeksiyonlar sayesinde korunan kişi sayısı 12 Nisan'da yüzde 73,4'e çıkacağı bildirilirken bu rakamın ülkeyi sürü bağışıklığına kavuşturmaya yetecek oran olduğu belirtildi.
Araştırma raporunda 14 Mart'tan bu yana 7,1 milyon kişiye daha aşı uygulandığı belirtilirken, aynı zamanda ülkede 24 gün içerisinde yaklaşık 100 bin yeni Kovid-19 vakası tespit edildiği bildirildi.
DOĞUŞTAN BAĞIŞIKLIK VAR MI?
Araştırmada yer alan uzmanlar her 10 kişiden birinin daha önce gerçekleşen enfeksiyonlar (koronavirüsün farklı türleri) nedeniyle doğuştan bağışıklığı olduğu belirtirken bunun dışında kalan kişilerin de hücreleri sayesinde bağışıklık kazandığı açıklandı.
Araştırma ekibinden UCL profesörü Karl Friston, "Sürü bağışıklığı tahminleri beni şaşırttı" ifadesini kullanırken, "Bağışıklığı tetikleme açısından aşılamanın tahmini etkinliği hesaba katılırken, bu modele göre nüfusun yaklaşık yüzde 70'inin bağışık olduğu anlamına geliyor" ifadelerini kullandı.
SÜRÜ BAĞIŞIKLIĞI NEDİR?
Sürü bağışıklığı sürü etkisi , topluluk bağışıklığı , nüfus bağışıklığı veya sosyal bağışıklık olarak da adlandırılır. Bireylerin büyük bir kısmının bağışıklığa sahip olduğu bir popülasyonda, bu tür insanların hastalık bulaşmasına katkıda bulunma olasılığı düşüktür, enfeksiyon zincirlerinin bozulma olasılığı daha yüksektir, bu da hastalığın yayılmasını durdurur veya yavaşlatır.
Bir toplumdaki bağışıklık bireylerinin oranı ne kadar büyük olursa, bağışıklık sahibi olmayan kişilerin bulaşıcı bir bireyle temas etme olasılığı o kadar az olur, bu da bağışıklık olmayan bireylerin enfeksiyondan korunmasına yardımcı olur.
Bireyler, daha erken bir enfeksiyondan iyileşme veya aşılama yoluyla bağışıklık kazanabilir. Belirli bir eşik değere ulaşıldığında, sürü bağışıklığı, bir popülasyondaki hastalığı yavaş yavaş ortadan kaldırır. Bu eliminasyon, dünya çapında başarılırsa, eradikasyon adı verilen enfeksiyon sayısında sıfıra kalıcı bir azalma ile sonuçlanabilir.
DSÖ "AHLAK DIŞI" DEMİŞTİ
Ghebreyesus, son günlerde virüsün yayılmasına izin vererek, sözde "sürü bağışıklığına ulaşma" kavramı hakkında bazı tartışmalar yaşandığına dikkati çekerek, aslında "sürü bağışıklığının" aşılama için kullanılan bir terim olduğunu vurgulamıştı. "Örneğin, kızamığa karşı sürü bağışıklığı, nüfusun yaklaşık yüzde 95'inin aşılanmasını gerektirir." diyen Ghebreyesus, kalan yüzde 5'inin ise kızamığın aşılananlar arasında yayılmamasıyla korunacağına işaret etmişti.
Ghebreyesus, "Diğer bir ifadeyle sürü bağışıklığı, insanları virüse maruz bırakarak değil, virüsten korumakla sağlanır." uyarısını yapmıştı.
Kaynak: www.haberler.com
YORUMLAR
FACEBOOK YORUM
İLGİNİZİ ÇEKEBİLECEK DİĞER GÜNDEM Haberleri
- BUGÜN
- BU HAFTA
- BU AY
- HABERLER
- VİDEOLAR
| Takım | O | G | M | B | A | Y | P | AV |
|---|
| Takım | O | G | M | B | A | Y | P | AV |
|---|
| Takım | O | G | M | B | A | Y | P | AV |
|---|
| Takım | O | G | M | B | A | Y | P | AV |
|---|
| Tarih | Ev Sahibi | Sonuç | Konuk Takım |
|---|
| Tarih | Ev Sahibi | Sonuç | Konuk Takım |
|---|
| Tarih | Ev Sahibi | Sonuç | Konuk Takım |
|---|
| Tarih | Ev Sahibi | Sonuç | Konuk Takım |
|---|













 Liyakat-Sen; mesai saatleri dışında hizmet içi eğitim faaliyetlerinde görevlendi..
Liyakat-Sen; mesai saatleri dışında hizmet içi eğitim faaliyetlerinde görevlendi.. İstanbul Bilgi Üniversitesinin faaliyet izninin iptaline ilişkin karar, Resmi Ga..
İstanbul Bilgi Üniversitesinin faaliyet izninin iptaline ilişkin karar, Resmi Ga.. Aile ve Sosyal Hizmetler Bakanlığı’nın Türkiye genelinde başlattığı ‘Çocuklar Gü..
Aile ve Sosyal Hizmetler Bakanlığı’nın Türkiye genelinde başlattığı ‘Çocuklar Gü.. Gebze 4. Asliye Ceza Mahkemesi’nin 2026/235 Esas ve 2026/469 Karar sayılı dosyas..
Gebze 4. Asliye Ceza Mahkemesi’nin 2026/235 Esas ve 2026/469 Karar sayılı dosyas.. Türk Eğitim-Sen, şube ve okul müdürlerine verilen ücretsiz soruşturma görevlerin..
Türk Eğitim-Sen, şube ve okul müdürlerine verilen ücretsiz soruşturma görevlerin.. Aile ve Sosyal Hizmetler Bakanlığı tarafından ülke genelinde Sosyal Risk Haritas..
Aile ve Sosyal Hizmetler Bakanlığı tarafından ülke genelinde Sosyal Risk Haritas.. Katıldığımız bir "Güvenli Okul İklimi Toplantısı" panelinden zihnimde ağır bir t..
Katıldığımız bir "Güvenli Okul İklimi Toplantısı" panelinden zihnimde ağır bir t.. Hürriyetçi Sağlık Sen Genel Başkanı Muhammet Birinci Kocaeli - İzmit ilçe Sağlık..
Hürriyetçi Sağlık Sen Genel Başkanı Muhammet Birinci Kocaeli - İzmit ilçe Sağlık.. Türkiye Cumhuriyeti’nin kuruluş sürecinde, milletin bağımsızlık iradesini en güç..
Türkiye Cumhuriyeti’nin kuruluş sürecinde, milletin bağımsızlık iradesini en güç.. Kimisi "sadece İstanbul" dedi, kimisi "bir gün" dedi, kimisi "iki gün" dedi. Par..
Kimisi "sadece İstanbul" dedi, kimisi "bir gün" dedi, kimisi "iki gün" dedi. Par.. Milli Eğitim sisteminde disiplin soruşturmalarının yürütülmesi, hem hukuki hem d..
Milli Eğitim sisteminde disiplin soruşturmalarının yürütülmesi, hem hukuki hem d..